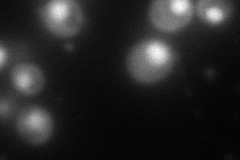
YLR437C
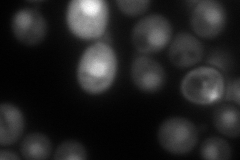
YLR437C
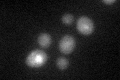
YLR437C
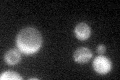
YLR437C

View description
Protein that regulates the nuclear localization of ribonucleotide reductase Rnr2p and Rnr4p subunits; phosphorylated by Dun1p in response to DNA damage and degraded; N-terminal half has similarity to S. pombe Spd1 protein
Localization:
Intensity:
Fold change:
Significance:
-
C’ GFP library in SD

nucleus49.91 -
N' NOP1pr-GFP in SD
below threshold0 -
N' TEF2pr-mCherry in SD
nucleus124.197 -
N' NATIVEpr-GFP in SD

nucleus30.884 -
N' TEF2pr-VC and Cyto-VN in SD

nucleus53.4577 -
C’ GFP library in SD+DTT
nucleus33.240.66No -
C’ GFP library in SD+H2O2
cytosolN/AN/ANo -
C’ GFP library in Starvation Media

nucleus24.020.48Yes -
C’ GFP library on the background of Pup2-DaMP

nucleus -
C’ GFP library on the background of CCT mutant

nucleus35.74330.716069No
